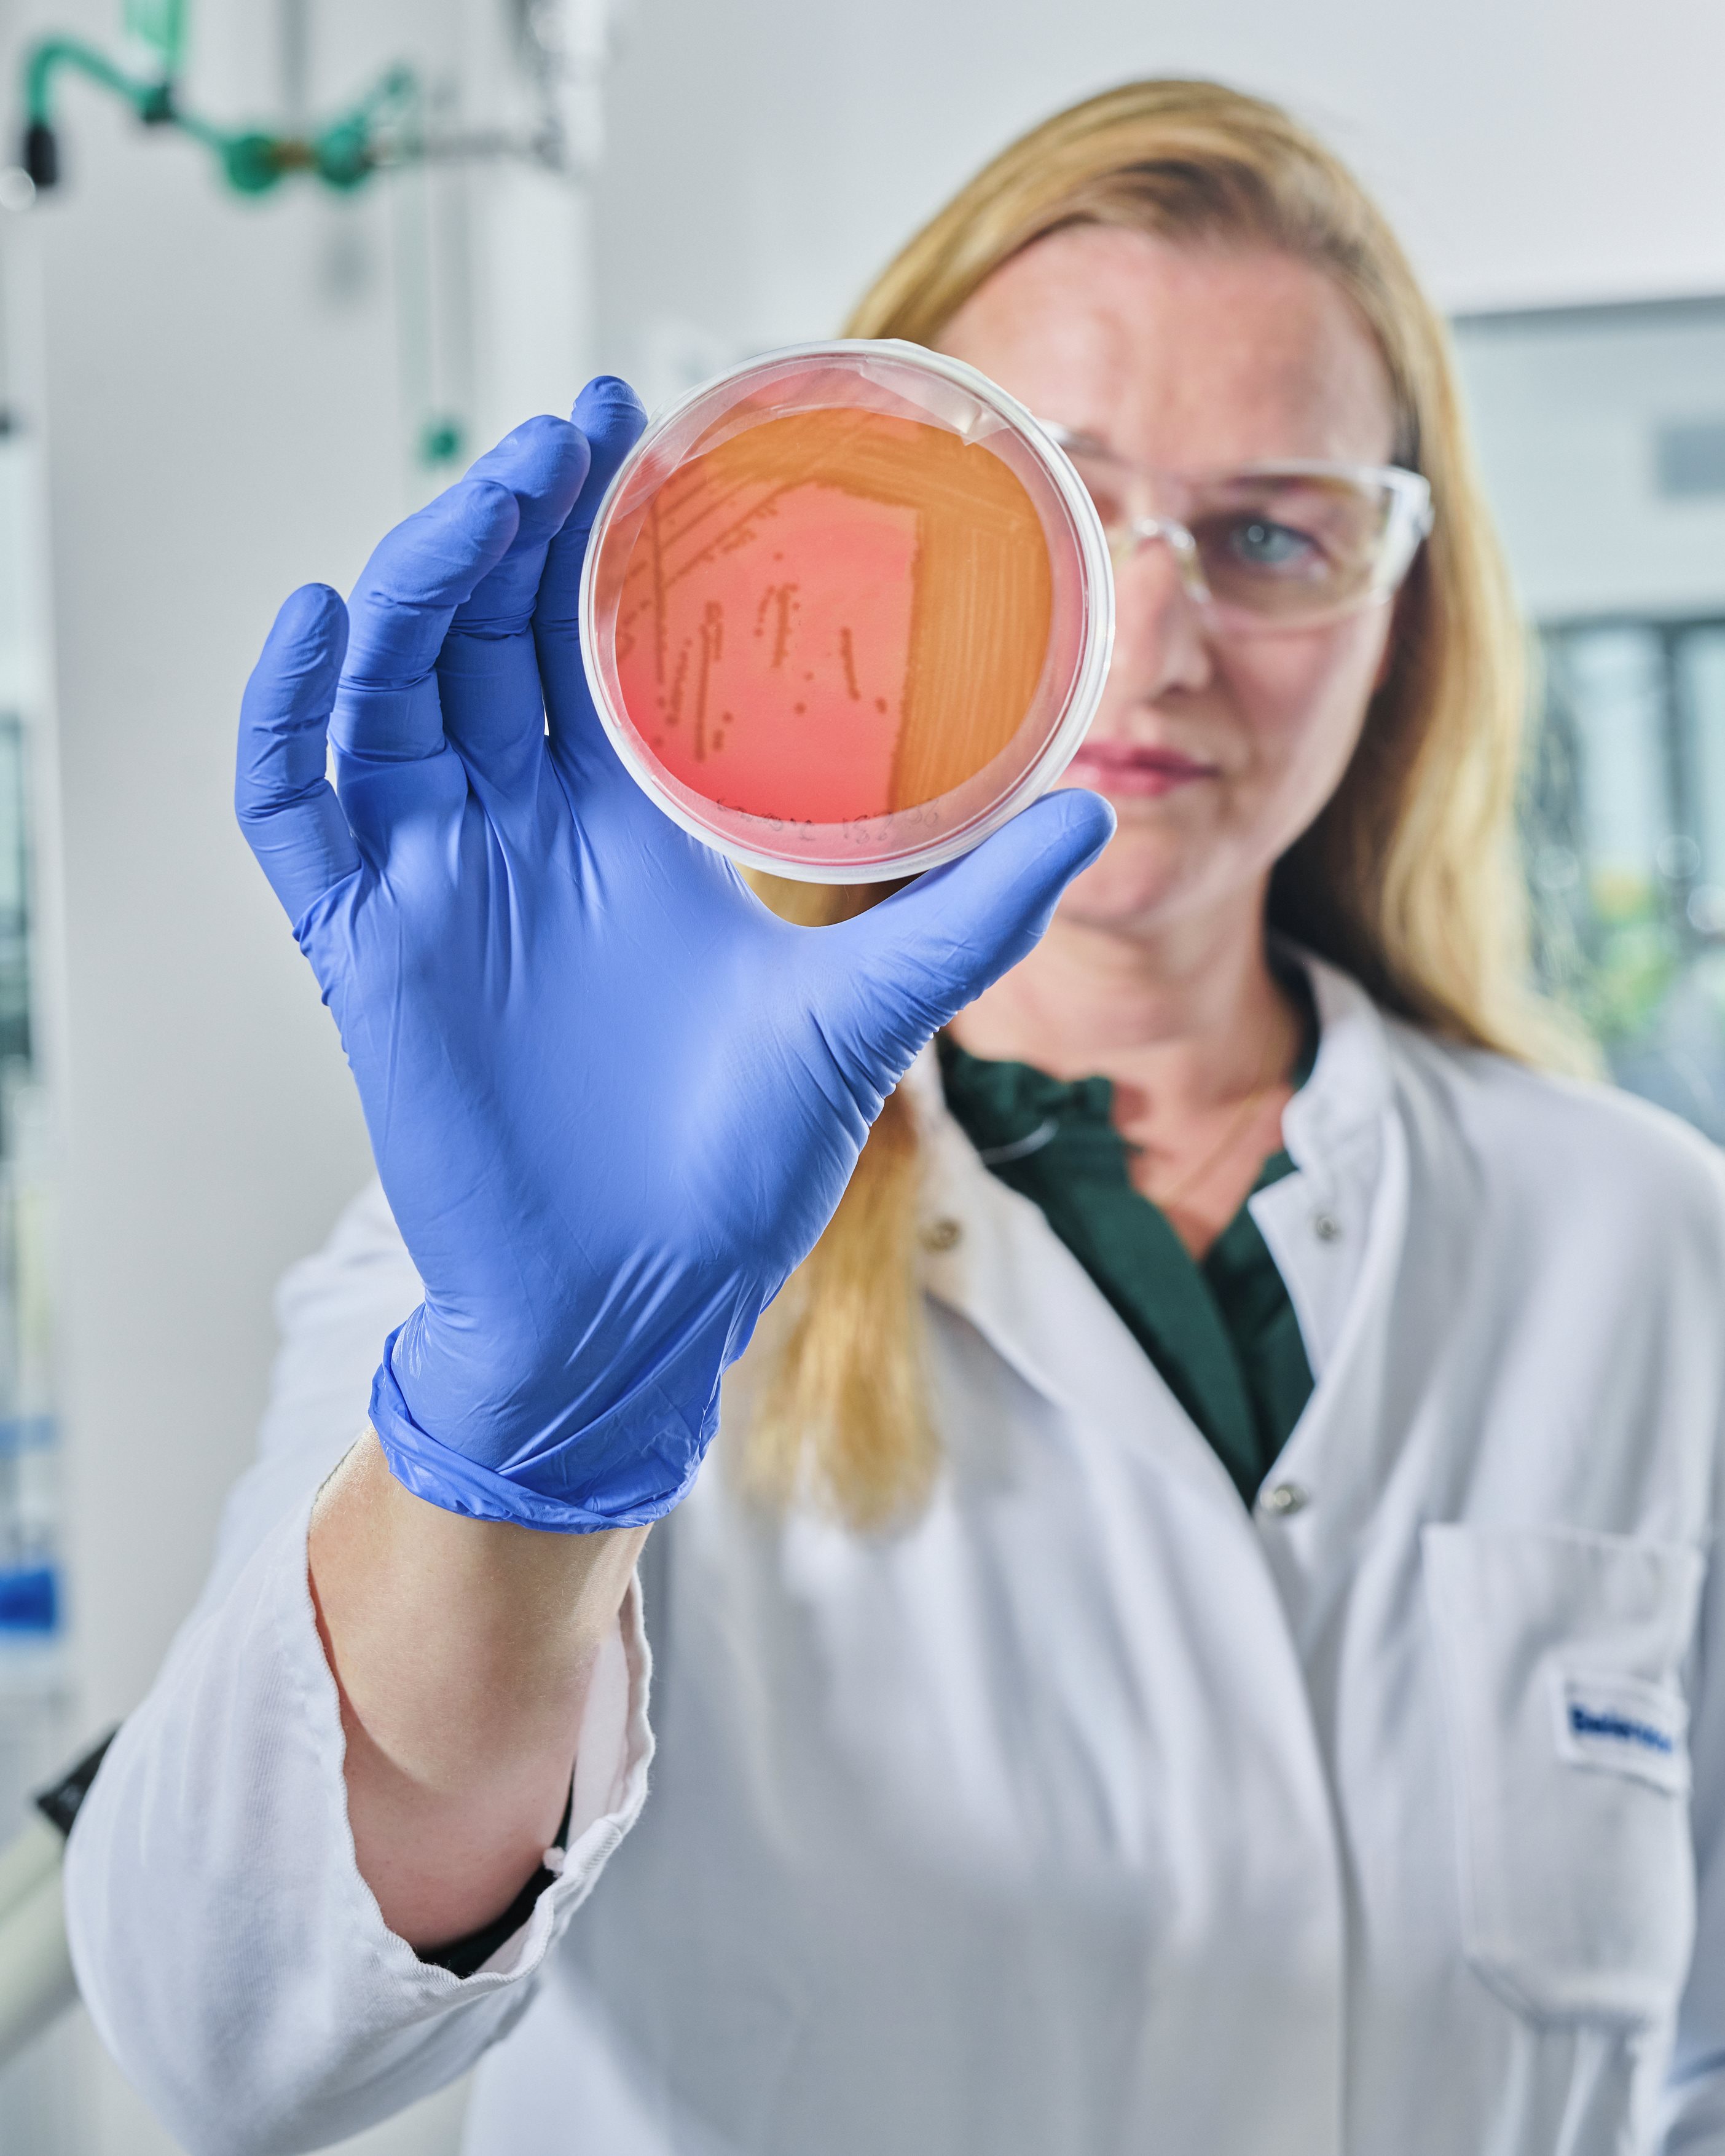

Innovation arises where disciplines meet. At Beiersdorf, we believe in the transformative power of collaborative research. Our success is built on strategic partnerships with leading experts worldwide – such as renowned research institutes, universities, start-ups, independent scientists and suppliers. By combining internal and external expertise, we challenge the status quo and shape the future of skin care together.

OUR OPEN INNOVATION APPROACH: HOW BEIERSDORF ENABLES COLLABORATION

Highlights of Beiersdorf Connect 2025